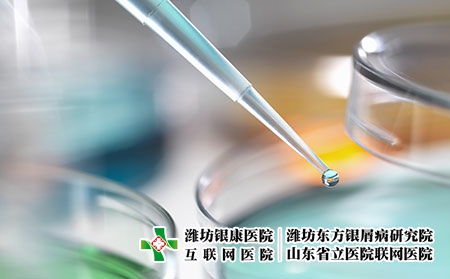
2 (431)

牛皮癬,這一慢性皮膚病,對于患者來說,無疑是一種身心雙重負擔。在眾多治療方法中,激光治療和熱處理備受關注。那么,這兩種治療方法究竟對牛皮癬有何作用呢?
激光治療牛皮癬,主要是利用激光的能量和特性,對皮膚進行有效的治療。激光能夠直接作用于皮損部位,通過刺激皮膚細胞的新陳代謝,促進色素的合成和皮膚的再生。同時,激光治療還能調整免疫系統的功能,從而減輕炎癥和瘙癢,達到治療的效果。然而,激光治療并非人人適用,其效果也會因個體差異而異。
熱處理,是另一種在牛皮癬治療中常用的物理療法。這種方法主要是利用高溫對皮膚產生熱效應,從而促進血液循環和新陳代謝,加速皮膚細胞的修復和再生。熱處理還可以幫助軟化皮膚,去除鱗屑,減輕瘙癢和疼痛。但需要注意的是,過高的溫度可能會對皮膚造成損傷,因此治療時溫度的控制非常重要。
當然,激光治療和熱處理都有其局限性。例如,激光治療可能會增加患皮膚癌的風險,而熱處理則可能不適用于所有牛皮癬患者。因此,在選擇治療方法時,患者應根據自身的情況,聽從醫生的建議,選擇適合自己的治療方法。
總的來說,激光治療和熱處理在牛皮癬治療中都有其獨特的作用。它們可以通過不同的機制,改善皮膚癥狀,提高患者的生活質量。但與此同時,我們也應理性看待這兩種治療方法,不盲目追求效果,而是要在確保安全的前提下,選擇合適的治療方法,堅持長期治療。
濰坊東方銀屑病醫院醫生說,提醒廣大牛皮癬患者,無論選擇何種治療方法,都應保持積極的心態,相信科學,相信醫生,相信自己能夠戰勝疾病。同時,也要注意保持良好的生活習慣,加強鍛煉,提高身體免疫力,為疾病的康復創造有利條件。